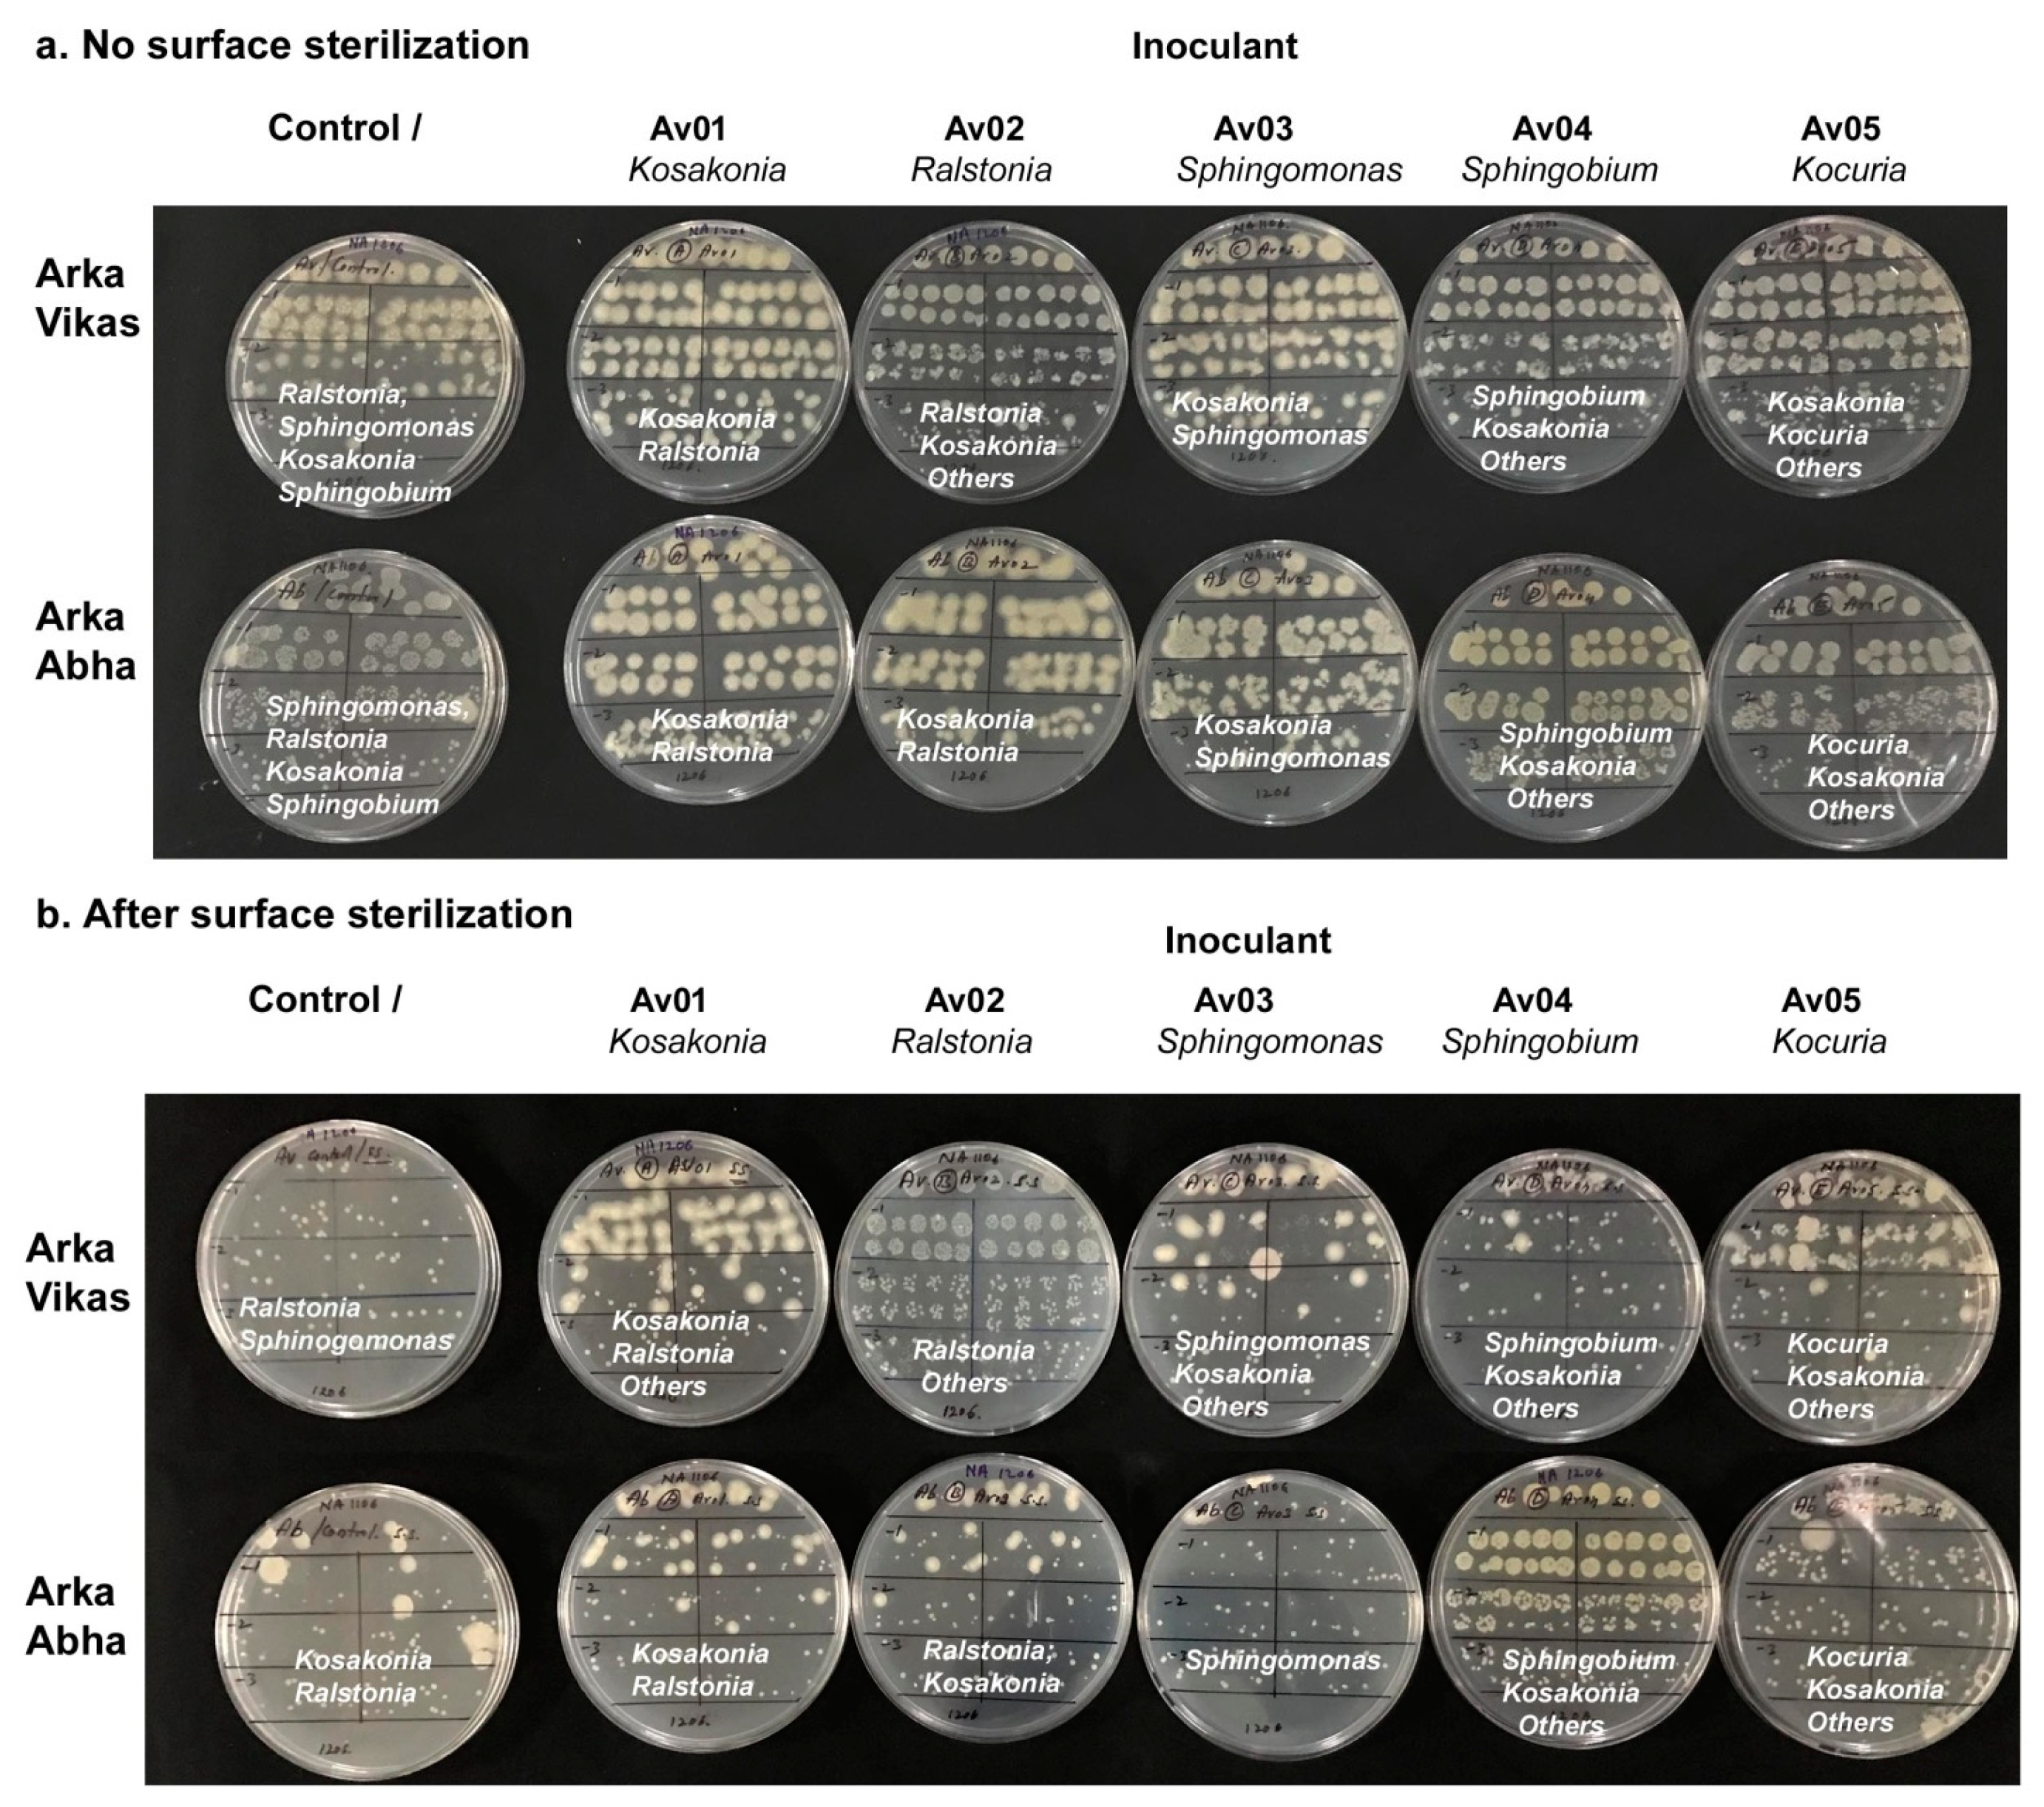
Microorganisms 07 00132 g005 Microorganisms 07 00132 g005

In Vitro Activation of Seed-Transmitted Cultivation-Recalcitrant Endophytic Bacteria in Tomato and Host–Endophyte Mutualism
Abstract
1. Introduction
2. Material and Methods
2.1. Seed Material and Experimental Set Up
2.2. Seed Surface Sterilization
2.3. Testing Homogenate from Seeds and Germinating Seeds for Cultivable Bacteria
2.4. Monitoring the Cotyledonary Stage In Vitro Seedlings for Bacterial Association
2.5. Testing One Month Old In Vitro Seedlings
2.6. Isolation and Identification of Endophytic Bacteria from BIP Seedlings
2.7. Isolation and Identification of Endophytic Bacteria from BIN Seedlings
2.8. Growth Assessment of Bacterial Isolates and Screening for Plant Growth Promotion (PGP) Characteristics
2.9. Assessing the Endophyte-Host Reliance Employing Host Tissue Extract
2.10. Assessing the Endophyte-Mediated Host Benefits In Vitro Trials
2.11. Testing the Re-Colonization Efficacy by Endophytic Bacterial Isolates
2.12. Monitoring of In Vitro Cultures at Different Phases of Growth and In Vitro Testing of Different Seed Lots
2.13. Experimental Design and Statistical Analysis
2.14. Accession Numbers
3. Results
3.1. Seed Surface Sterilization
3.2. Testing the Seed Homogenate and Germinating Seeds
3.3. Testing Cotyledonary Stage In Vitro Seedlings
3.4. Testing One Month Old In Vitro Seedlings
3.5. Isolation and Identification of Bacteria from BIP Seedlings
3.6. Isolation and Identification of Bacteria from BIN Seedlings
3.7. Growth of Isolates on Differential Media and PGP Characteristics
3.8. HTE-Based Host Reliance Assay
3.9. Endophyte-Mediated Host Benefits
3.10. Testing the Re-Colonization Efficacy of Endophytic Bacterial Isolates
3.11. Monitoring In Vitro Cultures at Different Phases of Growth and In Vitro Monitoring of Different Seed Lots
4. Discussion
Supplementary Materials
Author Contributions
Acknowledgments
Conflicts of Interest
Abbreviations
| ADW | Autoclaved distilled water |
| BIN | Bacteria index-negative |
| BIP | Bacteria index-positive |
| CREB | Cultivation recalcitrant endophytic bacteria |
| FDW | Filter-sterilized ADW |
| HTE | Host tissue extract |
| MS medium | Murashige and Skoog medium |
| NA | Nutrient agar |
| PGP | Plant growth promotion |
| SATS | Spotting-and-tilt-spreading |
| SP-SDS | Single plate-serial dilution spotting |
| SVI | Seedling vigour index |
| TH | Tissue homogenate |
| TSA | Trypticase soy agar |
| VBNC | Viable but non-cultivable |
| VBNYC | Viable-but-not-yet-cultivable |
References
- Hallman, J.; Quadt-Hallmann, A.; Mahaffee, W.F.; Kloepper, J.W. Bacterial endophytes in agricultural crops. Can. J. Microbiol. 1997, 43, 895–914. [Google Scholar] [CrossRef]
- Kandel, S.L.; Joubert, P.M.; Doty, S.L. Bacterial endophyte colonization and distribution within plants. Microorganisms 2017, 5, 77. [Google Scholar] [CrossRef]
- Hardoim, P.R.; van Overbeek, L.S.; Berg, G.; Pirttilä, A.M.; Compant, S.; Campisano, A.; Döring, M.; Sessitsch, A. The Hidden world within plants: Ecological and evolutionary considerations for defining functioning of microbial endophytes. Microbiol. Mol. Biol. Rev. 2015, 79, 293–320. [Google Scholar] [CrossRef] [PubMed]
- Frank, A.C.; Saldierna Guzmán, J.P.; Shay, J.E. Transmission of bacterial endophytes. Microorganisms 2017, 5, 70. [Google Scholar] [CrossRef] [PubMed]
- Liu, H.; Carvalhais, L.C.; Crawford, M.; Singh, E.; Dennis, P.G.; Pieterse, C.M.; Schenk, P.M. Inner plant values: Diversity, colonization and benefits from endophytic bacteria. Front. Microbiol. 2017, 8, 2552. [Google Scholar] [CrossRef]
- Podolich, O.; Ardanov, P.; Zaets, I.; Pirttilä, A.M.; Kozyrovska, N. Reviving of the endophytic bacterial community as a putative mechanism of plant resistance. Plant Soil 2015, 388, 367377. [Google Scholar]
- Thomas, P. Potential applications of endophytic microorganisms in agriculture. Asian Biotechnol. Dev. Rev. 2017, 19, 3–24. [Google Scholar]
- Bergna, A.; Cernava, T.; Rändler, M.; Grosch, R.; Zachow, C.; Berg, G. Tomato seeds preferably transmit plant beneficial endophytes. Phytobiomes J. 2019, 2, 183–193. [Google Scholar] [CrossRef]
- Goudjal, Y.; Toumatia, O.; Yekkour, A.; Sabaou, N.; Mathieu, F.; Zitouni, A. Biocontrol of Rhizoctonia solani damping-off and promotion of tomato plant growth by endophytic actinomycetes isolated from native plants of Algerian Sahara. Microbiol. Res. 2014, 169, 59–65. [Google Scholar] [CrossRef] [PubMed]
- Thomas, P.; Upreti, R. Evaluation of tomato seedling root-associated bacterial endophytes towards organic seedling production. Org. Agric. 2016, 6, 89–98. [Google Scholar] [CrossRef]
- O’Callaghan, M. Microbial inoculation of seed for improved crop performance: Issues and opportunities. Appl. Microbiol. Biotechnol. 2016, 100, 5729–5746. [Google Scholar] [CrossRef]
- Nelson, E.B. The seed microbiome: Origins, interactions and impacts. Plant Soil 2018, 422, 7–34. [Google Scholar] [CrossRef]
- Truyens, S.; Weyens, N.; Cuypers, A.; Vangronsveld, J. Bacterial seed endophytes: Genera, vertical transmission and interaction with plants. Environ. Microbiol. Rep. 2014, 7, 40–50. [Google Scholar] [CrossRef]
- Xu, M.; Sheng, J.; Chen, L.; Men, Y.; Gan, L.; Guo, S.; Shen, L. Bacterial community compositions of tomato (Lycopersicum esculentum Mill.) seeds and plant growth promoting activity of ACC deaminase producing Bacillus subtilis (HYT-12-1) on tomato seedlings. World J. Microbiol. Biotechnol. 2014, 30, 835–845. [Google Scholar] [CrossRef] [PubMed]
- López, S.; Pastorino, G.; Franco, M.; Medina, R.; Lucentini, C.; Saparrat, M.; Balatti, P. Microbial endophytes that live within the seeds of two tomato hybrids cultivated in Argentina. Agronomy 2018, 8, 136. [Google Scholar] [CrossRef]
- Adam, E.; Bernhart, M.; Müller, H.; Winkler, J.; Berg, G. The Cucurbita pepo seed microbiome: Genotype-specific composition and implications for breeding. Plant Soil 2018, 422, 35–49. [Google Scholar] [CrossRef]
- Glassner, H.; Zchori-Fein, E.; Yaron, S.; Sessitsch, A.; Sauer, U.; Compant, S. Bacterial niches inside seeds of Cucumis melo L. Plant Soil 2018, 422, 101–113. [Google Scholar] [CrossRef]
- Berg, G.; Raaijmakers, J.M. Saving seed microbiomes. ISME J. 2018, 12, 1167–1170. [Google Scholar] [CrossRef]
- White, J.F.; Kingsley, K.L.; Butterworth, S.; Brindisi, L.; Gatei, J.W.; Elmore, M.T.; Verma, S.K.; Yao, X.; Kowalski, K.P. Seed-vectored microbes: Their roles in improving seedling fitness and competitor plant suppression. In Seed Endophytes; Verma, S.K., White, J.F., Jr., Eds.; Springer: Cham, Switzerland, 2019; pp. 3–20. [Google Scholar]
- Hardoim, P. The ecology of seed microbiota. In Seed Endophytes; Verma, S.K., White, J.F., Jr., Eds.; Springer: Cham, Switzerland, 2019; pp. 103–126. [Google Scholar]
- Nelson, E.B.; Simoneau, P.; Barret, M.; Mitter, B.; Compant, S. Editorial special issue: The soil, the seed, the microbes and the plant. Plant Soil 2018, 422, 1–5. [Google Scholar] [CrossRef]
- Li, H.; Parmar, S.; Sharma, V.K.; White, J.F. Seed endophytes and their potential applications. In Seed Endophytes; Verma, S.K., White, J.F., Jr., Eds.; Springer: Cham, Switzerland, 2019; pp. 35–54. [Google Scholar]
- Robinson, R.J.; Fraaije, B.A.; Clark, I.M.; Jackson, R.W.; Hirsch, P.R.; Mauchline, T.H. Wheat seed embryo excision enables the creation of axenic seedlings and Koch’s postulates testing of putative bacterial endophytes. Sci. Rep. 2016, 6, 25581. [Google Scholar] [CrossRef] [PubMed]
- Rijavec, T.; Lapanje, A.; Dermastia, M.; Rupnik, M. Isolation of bacterial endophytes from germinated maize kernels. Can. J. Microbiol. 2007, 53, 802–808. [Google Scholar] [CrossRef]
- Thomas, P.; Swarna, G.K.; Patil, P.; Rawal, R.D. Ubiquitous presence of normally non-culturable endophytic bacteria in field shoot-tips of banana and their gradual activation to quiescent cultivable form in tissue cultures. Plant Cell Tissue Organ Cult. 2008, 93, 39–54. [Google Scholar] [CrossRef]
- Thomas, P. Intense association of non-culturable endophytic bacteria with antibiotic-cleansed in vitro watermelon and their activation in degenerating cultures. Plant. Cell Rep. 2011, 30, 2313–2325. [Google Scholar] [CrossRef]
- Thomas, P.; Sekhar, A.C. Cultivation versus molecular analysis of banana (Musa sp.) shoot-tip tissue reveals enormous diversity of normally uncultivable endophytic bacteria. Microb. Ecol. 2017, 73, 885–899. [Google Scholar] [CrossRef]
- Thomas, P.; Sekhar, A.C.; Mujawar, M.M. Non-recovery of varying proportions of viable bacteria during spread-plating governed by the extent of spreader usage and proposal for an alternate spotting-spreading approach to maximize the CFU. J. Appl. Microbiol. 2012, 113, 339–350. [Google Scholar] [CrossRef]
- Murashige, T.; Skoog, F. A revised medium for rapid growth and bioassays with tobacco tissue cultures. Physiol. Plant 1962, 15, 473–497. [Google Scholar] [CrossRef]
- Thomas, P.; Sekhar, A.C.; Upreti, R.; Mujawar, M.M.; Pasha, S.S. Optimization of single plate-serial dilution spotting (SP-SDS) with sample anchoring as an assured method for bacterial and yeast cfu enumeration and single colony isolation from diverse samples. Biotechnol. Rep. 2015, 8, 45–55. [Google Scholar] [CrossRef]
- Thomas, P. A three-step screening procedure for detection of covert and endophytic bacteria in plant tissue cultures. Curr. Sci. 2004, 87, 67–72. [Google Scholar]
- Li, C.Y.; Zhou, Y.L.; Ji, J.; Gu, C.T. Reclassification of Enterobacter oryziphilus and Enterobacter oryzendophyticus as Kosakonia oryziphila comb. nov. and Kosakonia oryzendophytica comb. nov. Int. J. Syst. Evol. Microbiol. 2016, 66, 2780–2783. [Google Scholar] [CrossRef][Green Version]
- Rodríguez, C.E.; Mitter, B.; Barret, M.; Sessitsch, A.; Compant, S. Commentary: Seed bacterial inhabitants and their routes of colonization. Plant Soil 2018, 422, 129–134. [Google Scholar] [CrossRef]
- Compant, S.; Mitter, B.; Colli-Mull, J.G.; Gangl, H.; Sessitsch, A. Endophytes of grapevine flowers, berries and seeds: Identification of cultivable bacteria, comparison with other plant parts, and visualization of niches of colonization. Microb. Ecol. 2011, 62, 188–197. [Google Scholar] [CrossRef]
- Ambika, M.B.; Ratering, S.; Rusch, V.; Schwiertz, A.; Geissler-Plaum, R.; Cardinale, M.; Schnell, S. Bacterial microbiota associated with flower pollen is influenced by pollination type, and shows a high degree of diversity and species-specificity. Environ. Microbiol. 2016, 18, 5161–5174. [Google Scholar] [CrossRef]
- Mitter, B.; Pfaffenbichler, N.; Flavell, R.; Compant, S.; Antonielli, L.; Petric, A.; Berninger, T.; Naveed, M.; Sheibani-Tezerji, R.; von Maltzahn, G.; et al. A new approach to modify plant microbiomes and traits by introducing beneficial bacteria at flowering into progeny seeds. Front. Microbiol. 2017, 8, 11. [Google Scholar] [CrossRef]
- Oliver, J.D. The viable but nonculturable state in bacteria. J. Microbiol. 2005, 43, 93–100. [Google Scholar]
- Thomas, P.; Soly, T.A. Endophytic bacteria associated with growing shoot tips of banana (Musa sp.) cv. Grand Naine and the affinity of endophytes to the host. Microb. Ecol. 2009, 58, 952–964. [Google Scholar] [CrossRef]
- Thomas, P.; Sekhar, A.C.; Pasha, S.S. High taxonomic diversity of cultivation-recalcitrant endophytic bacteria in grapevine field shoots, their in vitro introduction and unsuspected persistence. Planta 2017, 246, 879–898. [Google Scholar] [CrossRef]
- Thomas, P.; Agrawal, M.; Bharathkumar, C.B. Diverse cellular colonizing endophytic bacteria in field shoots and in vitro cultured papaya with physiological and functional implications. Physiol. Plant 2018. [Google Scholar] [CrossRef]
- Hardoim, P.R.; Nazir, R.; Sessitsch, A.; Elhottova, D.; Korenblum, E.; van Overbeek, L.S.; van Elsas, J.D. The new species Enterobacter oryziphilus sp. nov. and Enterobacter oryzendophyticus sp. nov. are key inhabitants of the endosphere of rice. BMC Microbiol. 2013, 13, 164. [Google Scholar] [CrossRef]
- Yang, S.; Zhang, X.; Cao, Z.; Zhao, K.; Wang, S.; Chen, M.; Hu, X. Growth-promoting Sphingomonas paucimobilis ZJSH 1 associated with Dendrobium officinale through phytohormone production and nitrogen fixation. Microb. Biotechnol. 2014, 7, 611–620. [Google Scholar] [CrossRef]
- Zhao, Q.; Hu, H.; Wang, W.; Peng, H.; Zhang, X. Genome sequence of Sphingobium yanoikuyae B1, a polycyclic aromatic hydrocarbon-degrading strain. Genome Announc. 2015, 3, e01522-14. [Google Scholar] [CrossRef]
- Prakash, O.; Nimonkar, Y.; Munot, H.; Sharma, A.; Vemuluri, V.R.; Chavadar, M.S.; Shouche, Y.S. Description of Micrococcus aloeverae sp. nov., an endophytic actinobacterium isolated from Aloe vera. Int. J. Syst. Evol. Microbiol. 2014, 64, 3427–3433. [Google Scholar] [CrossRef]
- Das, P.P.; Medhi, T. Isolation and molecular identification of four culturable endophytes from TV22 clone of Camellia sinensis (L.). Ann. Plant Sci. 2018, 7, 2119–2125. [Google Scholar] [CrossRef][Green Version]
- Khalaf, E.M.; Raizada, M.N. Taxonomic and functional diversity of cultured seed associated microbes of the cucurbit family. BMC Microbiol. 2016, 16, 131. [Google Scholar] [CrossRef]
- Mano, H.; Tanaka, F.; Watanabe, A.; Kaga, H.; Okunishi, S.; Morisaki, H. Culturable surface and endophytic bacterial flora of the maturing seeds of rice plants (Oryza sativa) cultivated in a paddy field. Microbes Environ. 2006, 21, 86–100. [Google Scholar] [CrossRef]
- Hardoim, P.R.; Hardoim, C.C.; van Overbeek, L.S.; van Elsas, J.D. Dynamics of seed-borne rice endophytes on early plant growth stages. PLoS ONE 2012, 7, e30438. [Google Scholar] [CrossRef]
- Weise, T.; Kai, M.; Piechulla, B. Bacterial ammonia causes significant plant growth inhibition. PLoS ONE 2013, 8, e63538. [Google Scholar] [CrossRef]
- Johnston-Monje, D.; Lundberg, D.S.; Lazarovits, G.; Reis, V.M.; Raizada, M.N. Bacterial populations in juvenile maize rhizospheres originate from both seed and soil. Plant Soil 2016, 405, 337–355. [Google Scholar] [CrossRef]
- Upreti, R.; Thomas, P. Root-associated bacterial endophytes from Ralstonia solanacearum resistant and susceptible tomato cultivars and their pathogen antagonistic effects. Front. Microbiol. 2015, 6, 255. [Google Scholar] [CrossRef]
- Tyc, O.; van den Berg, M.; Gerards, S.; van Veen, J.A.; Raaijmakers, J.M.; De Boer, W.; Garbeva, P. Impact of interspecific interactions on antimicrobial activity among soil bacteria. Front. Microbiol. 2014, 5, 567. [Google Scholar] [CrossRef]

| S. No. | Isolate | 16S seq. (bp) | Closest NCBI Type Strain † | Closest RDP Match and Score † | Suggested ID and Taxonomic Class | Gram Reaction |
|---|---|---|---|---|---|---|
| Isolates from Arka Vikas | ||||||
| 01 | IPS. Av01 | 820 | Enterobacter oryzendophyticus (NR.125586; 99%) | Kosakonia arachidis (S002151030; 0.921) | Kosakonia oryzendophyticaΨ; γ- Proteobacteria | -ve |
| 02 | IPS. Av02 | 810 | Ralstonia pickettii (LN681565; 99%) | Ralstonia pickettii (S000425929; 0.947) | Ralstonia pickettii; β- Proteobacteria | -ve |
| 03 | IPS. Av03 | 790 | Sphingomonas paucimobilis (LN681566; 100%) | Sphingomonas paucimobilis (S000437516; 0.993) | Sphingomonas paucimobilis; α- Proteobacteria | -ve |
| 04 | IPS. Av04 | 802 | Sphingobium yanoikuyae (LT899948; 99%) | Sphingobium yanoikuyae (S000413467; 0.914) | Sphingobium yanoikuyae; α- Proteobacteria | -ve |
| Isolates from Arka Abha | ||||||
| 01 | IPS. Ab01 | 820 | Enterobacter oryzendophyticus (NR.125586; 99%) | Kosakonia arachidis (S002151030; 0.906) | Kosakonia oryzendophyticaΨ; γ- Proteobacteria | -ve |
| 02 | IPS. Ab02 | 800 | Sphingomonas paucimobilis (NR118806; 100%) | Sphingomonas paucimobilis (S000437516; 0.983) | Sphingomonas paucimobilis; α- Proteobacteria | -ve |
| 03 | IPS. Ab03 | 805 | Ralstonia pickettii (NR_043152; 99%) | Ralstonia pickettii (S000425929; 0.933) | Ralstonia pickettii; β- Proteobacteria | -ve |
| 04 | IPS. Ab04 | 790 | Sphingobium yanoikuyae (LT899948; 99%) | Sphingobium yanoikuyae (S000413467; 0.939) | Sphingobium yanoikuyae; α- Proteobacteria | -ve |
| 05 | IPS. Ab05 | 745 | Ralstonia pickettii (LN681565; 99%) | Ralstonia pickettii (S000425929; 0.933) | Ralstonia pickettii; β- Proteobacteria | -ve |
| 06 | IPS. Ab06 | 730 | Sphingomonas paucimobilis (LN681566; 100%) | Sphingomonas paucimobilis (S000437516; 0.986) | Sphingomonas paucimobilis; α- Proteobacteria | -ve |
| 07 | IPS. Ab07 | 840 | Micrococcus aloeverae (NR. 134088; 100%) | Micrococcus aloeverae (S004054721; 0.996) | Micrococcus aloeverae; Actinobacteria | +ve |
| 08 | IPS. Ab08 | 840 | Ralstonia mannitolilytica (NR.025385; 99%) | Ralstonia pickettii (S000425929; 0.948) | Ralstonia mannitolilytica; β- Proteobacteria | -ve |
| 09 | IPS. Ab09 | 840 | Brachybacterium conglomeratum (NR.104689; 99%) | Brachybacterium paraconglomeratum (S000446670; 0.971) | Brachybacterium conglomeratum; Actinobacteria | +ve |
| S. No. | Isolate | 16S seq. (bp) | Closest NCBI Type Strain † | Closest RDP Type Strain and Homology † | Suggested ID and Taxonomic Class | Gram Reaction |
|---|---|---|---|---|---|---|
| Isolates from Arka Vikas | ||||||
| 01 | INS. Av. 01 | 795 | Sphingomonas paucimobilis (LN681566; 100%) | Sphingomonas paucimobilis (S000437516; 0.989) | Sphingomonas paucimobilis; α- Proteobacteria | -ve |
| 02 | INS. Av. 02 | 850 | Kocuria subflava (NR 144586; 96%) | Kocuria polaris (S000130611; 0.856) | Kocuria sp.; Actinobacteria | +ve |
| Isolates from Arka Abha | ||||||
| 01 | INS. Ab. 01 | 815 | Micrococus aloevereae (NR. 134088; 100%) | Micrococcus aloeverae (S004054721; 0.990) | Micrococus aloevereae; Actinobacteria | +ve |
| 02 | INS. Ab. 02 | 840 | Bacillus phocheonensis (NR.014377; 98%) | Bacillus niacini (S000014510; 0.879) | Bacillus sp.; Firmicutes | -ve |
| Isolate Code | Isolate ID | Identity of the Organism | Original Code | Colony Growth/Characteristics | Cell Morphology (d2- NA) | CFU mL−1 of 0.1 OD NA Culture | PGP characteristics | |||||||
|---|---|---|---|---|---|---|---|---|---|---|---|---|---|---|
| MSP S− | MSP S+ | MSA S− | MSA S+ | NA/TSA | N-Fixation | Ammonia Production | P-Solubil-Ization | Indole Production | ||||||
| Isolates from Arka Vikas BIP and BIN seedling sources (NCBI 16S rRNA gene accession numbers MK039407 to MK039411) | ||||||||||||||
| A | Tm.Vt-SE.Av01 | Kosakonia oryzendophytica | IPS. Av 01 | - | + | ++ | +++ | +++++; Fast growing fluidy white | Medium size rods | 6.50 × 107 | - | ++ | - | - |
| B | Tm.Vt-SE.Av02 | Ralstonia pickettii | IPS. Av 02 | - | + | ++ | ++ | +++; White, medium growth | Small rods | 1.50 × 107 | - | ++ | + | - |
| C | Tm.Vt-SE.Av03 | Sphingomonas paucimobilis | IPS. Av 03 | - | ++ | ++ | ++ | +++; Yellow, medium growth | Small rods | 3.10 × 108 | - | +++ | - | - |
| D | Tm.Vt-SE.Av04 | Sphingobium yanoikuyae | IPS. Av 04 | - | + | + | ++ | +++; Light yellow; medium growth | Small rods | 1.35 × 108 | - | ++ | - | - |
| E | Tm.Vt-SE.Av05 | Kocuria subflava | INS. Av 02 | - | - | + | ++ | +++; Slow white growth | Cocci | 7.5 × 106 | - | +++ | ||
| Isolates from Arka Abha BIP and BIN seedling sources (NCBI 16S rRNA gene accession numbers MK039412 to MK039419) | ||||||||||||||
| a | Tm.Vt-SE.Ab01 | Kosakonia oryzendophytica | IPS. Ab.01 | - | + | + | +++ | +++++; Fast growing fluidy white | Medium size rods | 9.50 × 107 | - | ++ | - | - |
| b | Tm.Vt-SE.Ab02 | Ralstonia pickettii | IPS. Ab.03 | - | + | + | ++ | +++; White, medium growth | Small rods | 2.50 × 108 | - | + | + | - |
| c | Tm.Vt-SE.Ab03 | Sphingomonas paucimobilis | IPS. Ab.02 | - | ++ | + | ++ | +++; Yellow, medium growth | Small rods | 2.10 × 108 | - | ++ | - | - |
| d | Tm.Vt-E.Ab04 | Sphingobium yanoikuyae | IPS. Ab.04 | - | + | + | ++ | +++; Light yellow; medium growth | Small rods | 1.45 × 108 | - | +++ | - | - |
| e | Tm.Vt-SE.Ab05 | Micrococus aloeverae | IPS. Ab.07 | - | + | - | ++ | +++; Yellow; Slow growth | Cocci | - | - | - | - | - |
| f | Tm.Vt-SE.Ab06 | Ralstonia mannililtolilytica | IPS. Ab.08 | - | + | + | ++ | +++; Cream, medium growth | Medium rods | 2.45 × 108 | - | ++ | + | - |
| g | Tm.Vt-SE.Ab07 | Brachybacterium conglomeratum | IPS. Ab.09 | - | - | ++ | +++’ Light yellow; slow growth | Cocci | 1.5 × 108 | - | - | + | - | |
| h | Tm.Vt-SE.Ab08 | Bacillus sp. | INS. Ab.02 | - | + | + | ++; Light cream flat; slow growth | Medium long rods | 8.50 × 107 | - | - | - | - | |
© 2019 by the authors. Licensee MDPI, Basel, Switzerland. This article is an open access article distributed under the terms and conditions of the Creative Commons Attribution (CC BY) license (http://creativecommons.org/licenses/by/4.0/).
Share and Cite
Shaik, S.P.; Thomas, P. In Vitro Activation of Seed-Transmitted Cultivation-Recalcitrant Endophytic Bacteria in Tomato and Host–Endophyte Mutualism. Microorganisms 2019, 7, 132. https://doi.org/10.3390/microorganisms7050132
Shaik SP, Thomas P. In Vitro Activation of Seed-Transmitted Cultivation-Recalcitrant Endophytic Bacteria in Tomato and Host–Endophyte Mutualism. Microorganisms. 2019; 7(5):132. https://doi.org/10.3390/microorganisms7050132
Chicago/Turabian StyleShaik, Sadiq Pasha, and Pious Thomas. 2019. "In Vitro Activation of Seed-Transmitted Cultivation-Recalcitrant Endophytic Bacteria in Tomato and Host–Endophyte Mutualism" Microorganisms 7, no. 5: 132. https://doi.org/10.3390/microorganisms7050132
APA StyleShaik, S. P., & Thomas, P. (2019). In Vitro Activation of Seed-Transmitted Cultivation-Recalcitrant Endophytic Bacteria in Tomato and Host–Endophyte Mutualism. Microorganisms, 7(5), 132. https://doi.org/10.3390/microorganisms7050132
